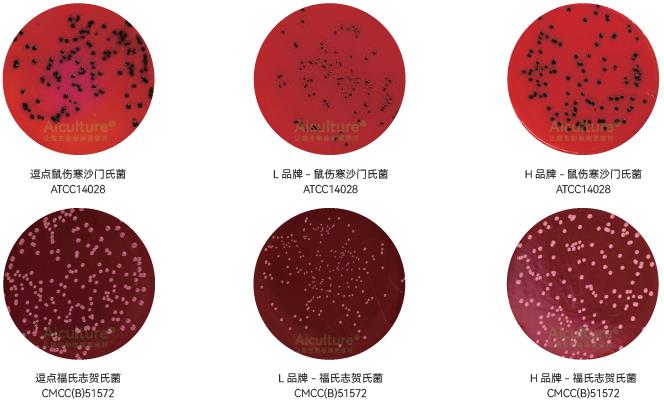

一、志贺氏菌的生物学特性
志贺菌属(Shigella)是人类细菌性痢疾最为常见的病原菌,通称痢疾杆菌,属肠杆菌科,革兰阴性无芽孢杆菌,无动力,无荚膜、无鞭毛、有菌毛,在营养培养基上生长良好。志贺菌常寄居在人及较高等猿类的肠道里,根据宿主的健康状况和年龄,一般只要10个菌体以上就能使人致病,其致病因素主要是侵袭力(菌毛)菌体内毒素以及个别菌株产生的外毒素。食品接触人员个人卫生差、从事食品加工行业人员患病或带菌者污染食品、存放已污染的食品温度不适当等是食源性志贺菌流行的最主要原因。
志贺菌属共有A、B、C、D四个亚群,分别是痢疾志贺菌、福氏志贺菌、鲍氏志贺菌和宋氏志贺菌,结合生化和血清上的各个特征可以区别四个亚群。A群主要由不发酵甘露醇的菌组成(有些菌株例外),其他三个亚群的菌都发酵甘露醇。B群中的菌在血清学上有内在联系,C群中的菌彼此之间或与其他亚群血清上是无关的,D群中的菌培养几天后一般能发酵乳糖和蔗糖。


二、检验步骤

三、样品处理及增菌
3.1样品的处理
以无菌操作取样25g(mL)加入装有灭菌225mL志贺氏菌增菌肉汤的均质容器中,常用均质容器有均质杯、锥形瓶、均质袋。
均质杯:多用于不易溶解的固体样品均质,可将固体样品切割搅拌均匀;
均质袋:可置于拍击式均质器中均质固体,常用于液体的均质;
锥形瓶:可置于摇床中,常用于液体的均质。
3.2增菌
均质后的样品置于41.5℃±1℃,厌氧培养16h-20h。厌氧培养可使用厌氧培养箱、厌氧培养盒和厌氧培养袋等, 志贺氏菌在志贺氏增菌肉汤中生长浑浊。
四、志贺氏菌的分离
取增菌后的志贺氏增菌液分别划线接种于XLD 琼脂平板和MAC 琼脂平板或志贺氏显色培养基平板上,于36℃ ±1℃需氧培养20h-24h。若出现的菌落不典型或菌落较小不易观察,则继续培养至48h 再进行观察。
4.1 XLD 琼脂平板
志贺氏菌在XLD 琼脂平板上的菌落特征为粉色至无色,半透明、光滑、湿润、圆形、边缘整齐或不齐菌落。志贺氏菌大多不发酵木糖、乳糖和蔗糖,可与发酵此三种糖类的细菌(如大肠黄色菌落)区分;志贺氏菌不产硫化氢,可与产硫化氢的细菌(如大部分沙门等)区分。
4.2 MAC 或志贺显色培养基
志贺氏菌在MAC 琼脂平板上的菌落特征为无色至浅粉红色,半透明、光滑、湿润、圆形、边缘整齐或不齐菌落。志贺氏菌大多不发酵乳糖产碱,故菌落颜色为红色,可与发酵乳糖产酸(菌落颜色为黄色,或有胆盐沉淀环)的细菌区分。部分宋内志贺氏菌迟缓发酵糖,若培养时间过长会产生粉色菌落,混淆结果。
 五、初步生化试验
五、初步生化试验自上述选择性平板上分别挑取2 个以上典型或可疑菌落,分别接种三糖铁琼脂(TSI)、半固体和营养琼脂斜面一管,置于36℃ ±1℃需氧培养20h-24h。
5.1 三糖铁琼脂志贺氏菌在三糖铁琼脂TSI 中:
①斜面产碱呈红色且底层产酸呈黄色(发酵葡萄糖,不发酵乳糖、蔗糖);
②不产气(福氏志贺氏菌6 型可产生少量气体);
③不产硫化氢。
 附录A
附录A
志贺氏菌增菌肉汤验证1、产品用途:用于志贺氏菌的选择性分离和初步鉴别。
2、检验原理:胰蛋白胨提供氮源,葡萄糖提供碳源满足细菌生长的需求;氯化钠可维持均衡的渗透压;磷酸二氢钾和磷酸氢二钾是缓冲剂;吐温80 是中和剂;新生霉素可抑制革兰氏阳性菌生长。



4、验证结果小结:
4.1 生长率:目标菌福氏志贺氏菌 CMCC(B)51572+ 金黄色葡萄球菌 ATCC6538,逗点、L 品牌、H 品牌均满足国标在XLD 上> 10CFU,
无色至粉红色,半透明菌落的要求;
4.2 选择性:金黄色葡萄球菌 ATCC6538,逗点、L 品牌、H 品牌均符合国标在TSA 上< 100CFU 要求;
4.3 感观:感观:逗点、L 品牌、H 品牌外观颜色无明显差异。
附录B
木糖赖氨酸脱氧胆盐琼脂(XLD) 验证1. 产品用途:用于沙门氏菌、志贺氏菌的分离培养。
2. 检验原理:酵母膏粉提供氮源、维生素、生长因子; 氯化钠维持均衡的渗透压;木塘、乳糖、蔗糖为可发酵糖类,产酸使酚红指示剂变黄;去氧胆酸钠抑制革兰氏阳性菌,但不影响沙门氏菌的生长;硫代硫酸钠可被某些细菌还原硫化氢,与柠檬酸铁铵中的铁盐生成黑色硫化铁;琼脂是培养基的凝固剂;酚红为pH 指示剂。




4、验证结果小结:
4.1 生长率:目标菌鼠伤寒沙门氏菌ATCC14028、福氏志贺氏菌 CMCC(B)51572 ,逗点、L 品牌、H 品牌均满足国标PR ≥ 0.7 的要求。H品牌菌落生长速度更快,菌落特征更明显,L 品牌生长速度较缓慢;
4.2 选择性:大肠埃希氏菌 ATCC 25922 ,逗点、L 品牌均满足国标G < 5 的要求,H 品牌G=5.5 ,不满足国标要求;金黄色葡萄球菌ATCC6538,逗点、L 品牌、H 品牌均满足国标G ≤ 1 的要求;
4.3 感观:三家平板颜色无显著差异。
4.4 生长性能,逗点和H 品牌优于L 品牌。特异性上(特别是对大肠的抑制)L 品牌更好。
附录C麦康凯琼脂(MAC)验证1. 产品用途:用于志贺氏菌的选择性分离
2. 检验原理:蛋白胨提供碳氮源;乳糖为可发酵的糖类;3 号胆盐和结晶紫可抑制革兰氏阳性菌的生长;氯化钠维持均衡的渗透压;中性红是pH 指示剂,细菌发酵乳糖产酸时菌落呈粉红色,并在菌落周围出现胆盐沉淀的浑浊圈。琼脂是培养基的凝固剂。

表7-3 :麦康凯琼脂(MAC)验证



4、验证结果小结:
4.1 生长率:目标菌大肠埃希氏菌ATCC25922,逗点、L 品牌、H 品牌均满足国标PR ≥ 0.5 的要求,H 品牌、L 品牌有明显胆酸盐沉淀,目标菌落较大,逗点无胆酸盐沉淀,标菌落较小; 福氏志贺氏菌 CMCC(B)51572,逗点、品牌、H 品牌均满足国标PR ≥ 0.5 的要求。
4.2 选择性:金黄色葡萄球菌 ATCC6538 ,逗点、品牌、H 品牌均满足国标G ≤ 1 的要求。
4.3 感观:三家平板颜色无显著差异。
附录D
志贺氏菌显色培养基验证1. 产品用途:用于志贺氏菌的选择性分离和初步鉴别。
2. 检验原理:蛋白胨和酵母膏粉提供碳氮源和微量元素;氯化钠可维持均衡的渗透压;琼脂是培养基的凝固剂;抑制剂抑制杂菌的生长;酚红是pH 指示剂,发酵糖产酸的菌呈黄色;混合色素对应的酶发生特异性反应,水解底物,释放出显色基团。

表7-4 :志贺氏菌显色培养基验证


4、验证结果小结:
4.1 生长率:目标菌福氏志贺氏菌 CMCC(B)51572、痢疾志贺氏菌 CMCC(B)51105 逗点、H 品牌均满足国标PR ≥ 0.5 的要求。H 品牌菌落
生长速度更快;
4.2 选择性:逗点、H 品牌金黄色葡萄球菌 ATCC 6538,逗点、H 品牌均满足国标G ≤ 1 的要求;
4.3 特异性:产气肠杆菌 ATCC13048、痢疾志贺氏菌 CMCC(B)51105 逗点、H 品牌均满足菌落颜色特征要求。
4.4 感观:两家平板颜色无显著差异。
4.5 2 家产品无明显差异,都满足国标。
附录E三糖铁琼脂(TSI)验证1、产品用途:用于鉴别肠道菌发酵蔗糖、乳糖、葡萄糖及产生硫化氢的生化反应。
2、检验原理:胨、牛肉浸出粉提供氮源、维生素、矿物质;乳糖、葡萄糖、蔗糖为可发酵糖类,其产酸时通过酚磺酞指示剂测出,酸性呈黄色,碱性呈红色;硫代硫酸钠可被某些细菌还原为硫化氢,与硫酸亚铁中的铁盐生成黑色硫化铁;氯化钠维持均衡的渗透压;琼脂是培养基的凝固剂。



4、验证结果小结:
4.1生化特性:目标菌大肠埃希氏菌ATCC25922、肠炎沙门氏菌CMCC(B)50335、福氏志贺氏菌ATCC12022、铜绿假单胞菌ATCC27853生长特性均符合国标要求;
4.2感观:逗点、L品牌、H品牌空白管无明显差异。
4.3三家产品无明显差别,在肠炎沙门氏菌上,L品牌更优秀-黑色菌更明显。